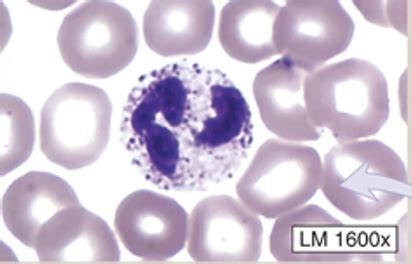
The Path O Less Taken Flashcards Quizlet

I’ll help you create a blog post about the medical term “Path” using the specified guidelines. I’ll use WebSearch to gather some accurate medical information first. Based on the search results, I’ll craft a blog post about the medical term “Path”:
The intricate world of medical science reveals a fascinating realm known as pathology, a term deeply rooted in understanding the complexities of human disease. Derived from the Greek words “pathos” (meaning disease) and “logos” (meaning study), pathology represents a critical branch of medical science that delves into the fundamental nature of illnesses and their profound impact on human health.
Understanding the Essence of Pathology

Pathology is far more than a simple medical discipline; it is the foundational science that unravels the mysteries of disease processes. Pathologists serve as medical detectives, examining tissues, bodily fluids, and cellular structures to diagnose and understand various medical conditions. Their work is instrumental in providing accurate diagnoses, guiding treatment strategies, and advancing medical knowledge.
Diverse Specialties Within Pathology

The field of pathology encompasses multiple specialized areas, each focusing on unique aspects of medical investigation:
- Surgical Pathology: Analyzing tissue samples to identify cancer, infections, and other abnormalities
- Forensic Pathology: Investigating causes of death through detailed examinations
- Cytopathology: Studying individual cells to detect potential diseases
- Hematopathology: Examining blood and lymphoid systems for disorders
The Critical Role of Pathological Research

Pathologists play a pivotal role in modern healthcare, contributing to medical diagnosis, research, and treatment planning. Their expertise extends beyond laboratory analysis, encompassing critical aspects of patient care across various medical specialties.
| Pathology Specialty | Primary Focus |
|---|---|
| Chemical Pathology | Analyzing chemical components in bodily fluids |
| Medical Microbiology | Detecting and characterizing infectious agents |
| Dermatopathology | Investigating skin-related diseases and conditions |

Technological Advancements in Pathology

Modern pathology has evolved dramatically with technological innovations. Digital pathology and advanced molecular diagnostic techniques have transformed how pathologists analyze and interpret medical data. These technological breakthroughs enable more precise diagnoses and personalized treatment approaches.
🔬 Note: Pathology continues to be a dynamic field, constantly adapting to new medical challenges and technological advancements.
The journey of understanding disease through pathology represents a testament to human curiosity and medical innovation. By examining the intricate details of cellular structures and disease mechanisms, pathologists continue to unlock critical insights that save lives and improve patient outcomes.
What exactly do pathologists do?
+
Pathologists analyze tissue samples, bodily fluids, and cells to diagnose diseases, guide treatment, and contribute to medical research by understanding disease mechanisms.
How long does it take to become a pathologist?

+
Becoming a pathologist typically requires completing a four-year undergraduate degree, four years of medical school, and an additional 3-4 years of residency training in pathology.
Are pathologists doctors?

+
Yes, pathologists are medical doctors (M.D. or D.O.) who specialize in diagnosing diseases through laboratory medicine and scientific examination.

